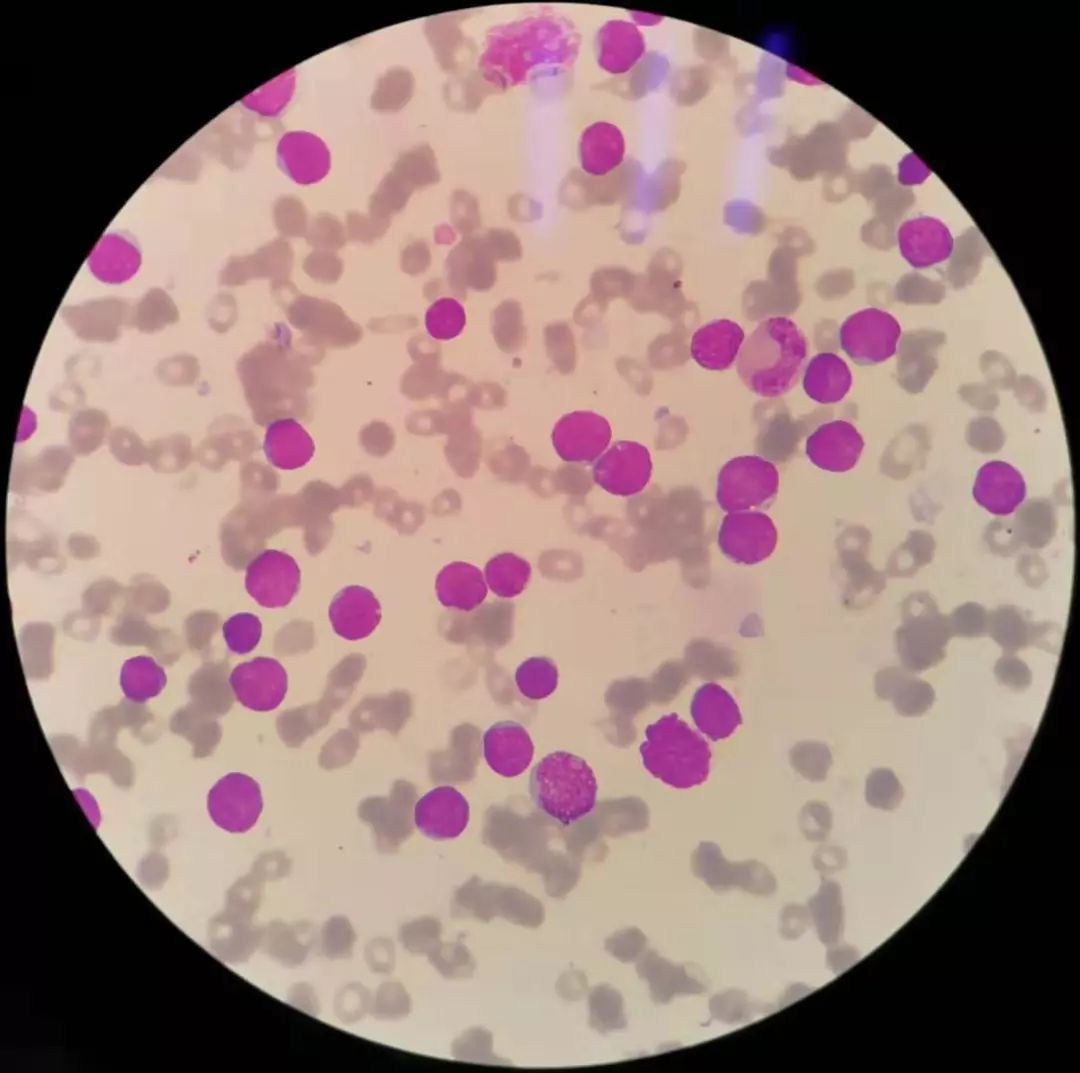
全血细胞减少就是白血病,全血细胞减少性白血病

作者 | 马庆峰
单位 | 肥城市人民医院
前 言
全血细胞减少病因复杂,如再生障碍性贫血、MDS(骨髓增生异常综合征)、急性白血病、自身免疫性疾病、肿瘤、失血等。结合血常规散点图及形态学镜检有助于发现线索,探寻疾病的本质。
案例经过与分析
患者为一青年女性,因全血细胞减少、乏力就诊,其血常规结果显示三系均不同程度减少:

仪器提示白细胞多种异常,散点图显示有少量原始细胞:

此结果已触发复检规则,仪器自动推片、染色。
低倍镜下可见白细胞减少:

油镜下可见约8%原始血细胞:

左右滑动查看更多
患者因此收治入院,复查血常规,其结果、散点图及镜下所见基本相同:

行骨髓穿刺,涂片,低倍镜下可见增生明显活跃:

油镜下可见原始细胞约占92%,片尾部细胞成堆分布、涂抹细胞易见,形态学诊断为急性白血病:
左右滑动查看更多
FCM(流式细胞学)诊断为Common-B-ALL[1]:

总结与心得
从全血细胞减少到Common-B急淋,至此已明确诊断,但从精准诊断、精准治疗角度仍需完善遗传学与分子生物学检查。在白血病的预后判断、选择治疗方案及后续的MRD(白血病微小残留检测)等整个治疗过程中,这些检查都会发挥重要作用[2]。

秦伟主任点评
急性淋巴细胞白血病白细胞计数多数增高,1/3的成人急淋白细胞可正常或减少。分类中原始及幼稚细胞增多。本文作者在审核报告时认真分析报警信息,按要求进行血片镜检。为临床及时提供进一步的诊疗建议。患者住院后通过骨髓形态学检查得出明确诊断。同时结合流式细胞学的结果进一步保证了诊断的正确。
(点评专家:秦伟,肥城市人民医院,医学检验科主任)
【参考文献】
[1] WHOClassification of Tumours of Haematoplietic and LymphoidTissues;Sleven H. Swerdlow,Elias Campo;2016,199-213
[2] 血液病诊疗规范;王建祥;2014;16-27
